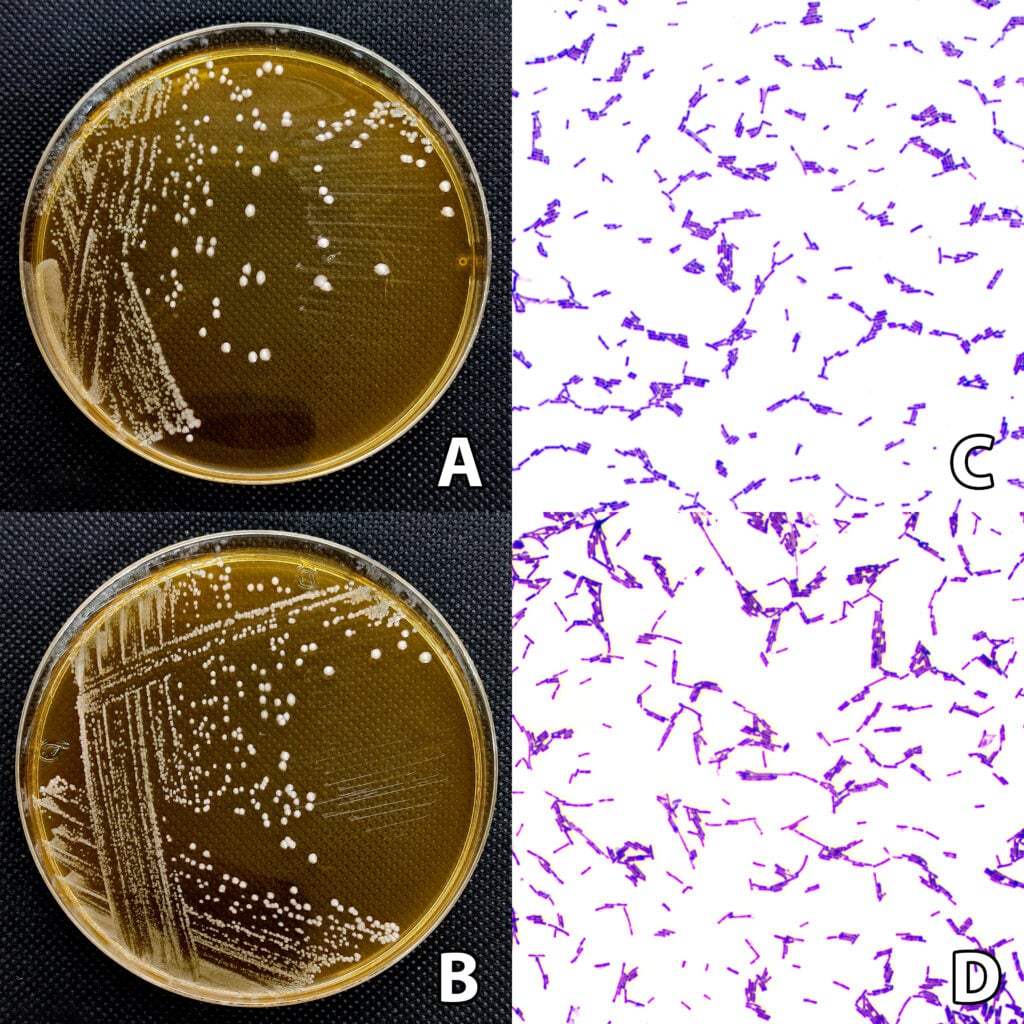

Research
As the national university, we champion and support innovative research that addresses the country’s most pressing challenges.
30 Jan 2026
Burong isda (fermented fish), indigenous to the Philippines, has probiotic potential for digestive and immune health
Fermented foods in the Philippines, such as burong isda (fermented fish), are not only part of our culinary heritage but...
Read More29 Jan 2026
The strength and structure of three commercially important bamboo species in the Philippines vary greatly by location
Timber shortages in the Philippines have increased demand for alternative materials such as bamboo, which is used as a substitute...
Read More28 Jan 2026
Researchers develop a model that helps companies make smarter choices in carbon trading
Carbon trading is a mechanism that allows entities to sell or purchase credits which indicate the right to emit carbon...
Read More27 Jan 2026
Around 1,500 social media influencer accounts were involved in covert or under-the-radar campaigning during the 2022 Philippine presidential elections
This study estimates the number of social media influencers on Facebook, Twitter, TikTok, and YouTube, and the amount of money...
Read More26 Jan 2026
Re-industrializing the domestic production base can greatly strengthen economic diversification in the Philippines
This paper builds on the broad argument that economic diversification can drive industrial upgrading and growth in an emerging economy...
Read More23 Jan 2026
Most students recognize the relevance of learning competencies in chemistry to sustainable development
Chemistry is deeply interconnected with various aspects of sustainability. However, enabling students to analyze these interconnections requires adequate support in...
Read More22 Jan 2026
Researchers develop a method for creating maps that show how national cultures have evolved over time
Culture is understood as a shared and negotiated system of meaning that people learn and practice by interpreting their experience...
Read More21 Jan 2026
Researchers design a potential mRNA vaccine against African swine fever using advanced computer-based methods
African swine fever (ASF) is a deadly disease that has severely impacted pig farming worldwide. In the Philippines, ASFV outbreaks...
Read More20 Jan 2026
A foreign-funded farm-to-market road project in Quezon worsened inequality by strengthening the power of rural elites
This study rigorously explored the multifaceted impacts of the Japanese-funded farm-to-market road (FMR) project in Agdangan, Quezon, focusing on its...
Read More19 Jan 2026
Filipina domestic workers in Singapore share some experiences with other overseas mothers but also face unique challenges
In this study, I looked at how single Filipina mothers working as domestic workers in Singapore maintain their familial ties,...
Read More16 Jan 2026
Close government–business relationships helped deliver major infrastructure projects in Iloilo City
This article examines Iloilo City as an alternative model of government–business relations, built on a stable local political system and...
Read More15 Jan 2026
Researchers develop a novel non-flooded time-series approach for improved global near-real-time flood mapping
Mapping flood events with Synthetic Aperture Radar (SAR) data is becoming increasingly important due to its spatiotemporal coverage and independence...
Read More